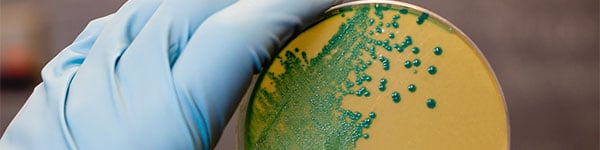

Category: Specific Microbe Control
Level: Advanced
Languages Available: Brazilian Portuguese, English, Dutch, French, German, Italian, Polish, Spanish.
Course Modules: Listeria Management in Food Processing
It is recommended that trainees have completed Principles of Hygiene and Sanitation in Food and Beverage Processing in preparation for this course.
Course Description:
Listeria poses a significant risk to the food industry. It is one of the most prevalent food pathogens and responsible for a high percentage of food-related illness. Combatting the risk requires action to be taken at all stages of the production process.
This advanced training course maps the interventions that can be implemented to reduce the risk of listeria contamination at the farm, in transit, during processing and packaging.
Suitable For:
Suitable for employees in the food industry, especially chilled products.
Learning Objectives:
The Diversey team offers the right people, technology and expertise to solve your most complex food and beverage challenges.